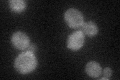
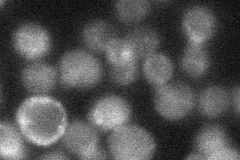
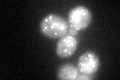
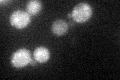
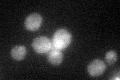

View description
Ser-Thr protein kinase, member (with Ark1p and Prk1p) of the Ark kinase family; involved in endocytosis and actin cytoskeleton organization
Localization:
Intensity:
Fold change:
Significance:
-
C’ GFP library in SD
cytosol37.78 -
N' NOP1pr-GFP in SD

cytosol,punctate,bud neck84.7497 -
N' TEF2pr-mCherry in SD

cytosol,cell periphery,punctate113.39 -
N' NATIVEpr-GFP in SD
below threshold28.2134 -
N' TEF2pr-VC and Cyto-VN in SD

cell periphery,punctate47.2114 -
C’ GFP library in SD+DTT
punctateN/AN/ANo -
C’ GFP library in SD+H2O2
cytosol44.521.17No -
C’ GFP library in Starvation Media
cytosol46.81.23No -
C’ GFP library on the background of Pup2-DaMP

cytosol -
C’ GFP library on the background of CCT mutant

cytosol42.40511.12234No
